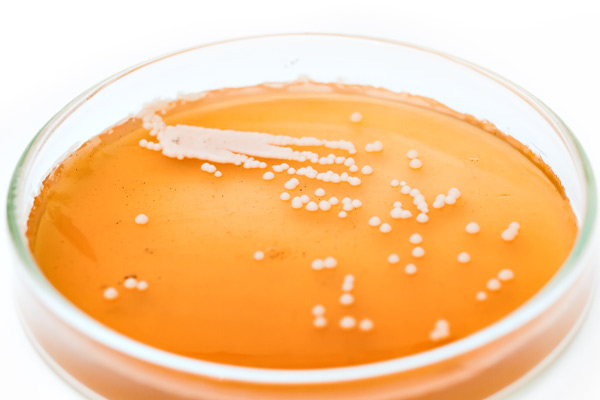
yeast

Hops get all the attention—all the fame, puns and glory while yeast does almost all the work. Hops dominate label space, and varieties like Cascade, Strata and Citra are practically house-hold names, thanks to the seemingly unquenchable demand for every category of IPA. Yet basic beer ale yeast Saccharomyces cerevisiae is abstract to most people, nearly unpronounceable, and no one talks about it at parties or gets tattoos of it at beer festivals. You can make beer without hops but you cannot make beer without yeast.
For all the bravado of hops, 79% of beer flavor descriptors are derived from or modified by yeast. In fact, every category of sensory description is affected by yeast. Yeast affects the aroma, mouthfeel, and appearance—it makes hazy IPA’s haze.
Fermentation is the process by which yeast eats sugars and metabolizes it into Co2 and alcohol. One of the most important elements of brewing is ensuring that the yeast is happy and healthy. If not, the beer will be terrible. Quality Control departments monitor yeast health so the beer is drinkable. Without quality control, you might as well just throw the hops in the garbage.
Yeast is all around us. Its spores are floating on dust particles in the air, and yeast even lives on our skin, invisible to the naked eye. Yeast is one of the oldest domesticated organisms, since brewing began in Mesopotamia around 5,000 BC. (Hops, on the other hand, were not commonly utilized for beer until the middle ages.)
William Bostwick writes in The Brewer’s Tale: A History According to Beer, “We don’t really make beer. Yeast does.” The brewer merely sets the stage for the yeast to perform the magic of fermentation. Bostwick writes, “Brewing beer is about taking control of nature, about taming that spore, transforming the raw into the cooked.” The hungry yeast spores are floating around ready to find a sweet meal and get to work. In the case of beer, the sugars come from malt.
Yeast can be controlled through temperature, time, and oxygen to ferment to the parameters we’ve set. Cultivating this wild, magic, invisible element eventually determined all the beer categories we enjoy today. Even though the role of yeast was not completely understood until Louis Pasteur’s microbiology work in the 19th century, brewers had been learning to domesticate yeast by adding some beer from the last batch (or a piece of wood soaked in it) into the new one to get a good brew. Thus, quality control existed by regrowing yeast from good batches of beer and dumping bad ones before there were labs with polymerase chain reaction (P.C.R.) tests.
During fermentation yeast also creates other flavors as it eats, or metabolizes the sugars. These metabolites include fruity esters, spicy, smoky phenols, fusel alcohols, buttery diacetyl, sulfur, acids, and more that are appropriate and definitive for beer styles—yet can be disgusting when they are above a certain threshold. Attenuation, how much sugars the yeast metabolize, is also important. It not only determines the alcohol content, but residual sugars have a huge impact on the sensory experience, and unattenuated beer could be a breeding ground for contaminates like bacteria and unwanted wild yeasts when unchecked.
In a quality control lab, the lab tech counts the yeast and determines how much of it is needed, the optimal time to harvest and pitch it, and monitors its health. PCR tests check for contamination. Does the beer have off flavors, is it ready for package, and does it fit the brand profile?
In a quality control lab, the lab tech counts the yeast and determines how much of it is needed, the optimal time to harvest and pitch it, and monitors its health. PCR tests check for contamination. Does the beer have off flavors, is it ready for package, and does it fit the brand profile?
“Quality control is so important. Every brewery should have a quality control department,” said Judy Elhamalawy, who developed the Quality Control program at Five Boroughs Brewing Co., a microbrewery in Brooklyn, NY.
“Under pitching leads to stress in the yeast. It has a harder time reabsorbing diacetyl, which increases tank residency time, which messes up the production schedule,” Elhamalawy said. “It could lead to yeast mutations and competing infections because the alcohol doesn’t get produced fast enough.”
“Over pitching leads to the yeast mutating to ‘lazier versions,’ which reduces efficiency and can mess up the production schedule,” she said, “Stressed yeast can lead to hydrogen sulfide, or rotten egg smell.”
After fermentation, the lab ensures that, on the micro level, the beer is up to the parameters for each brand. It is carbonated, clean, and good to leave the brewery. Once the beers are out in the world, according to Elhamalawy, “the worst thing bars can do to beers is not clean their lines.”
In addition to a lab, sensory panels are utilized to make sure the science is right and the quality is consistent, Quality Assurance. “We look at attributes for each brand, for example, our stout, and scale it within a range,” said Amanda Benson, Sensory Panel Coordinator at Deschutes Brewery in Bend, Oregon.
The panels can taste up to 15 samples to look for defects in the beer according to a range of sensory parameters for each brand. According to Benson, the house yeast is an English strain and prone to diacetyl and isoamyl acetate, an ester that produces banana flavor and smell, so they need to check that it is within an acceptable range.
If something is off, they will look at the recipe to see if there is something to fix. “A lot of times we just watch and wait,” she said. For example, Lil’ Squeezy, a juicy Pale Ale, had a trashy sulfur smell that was jarring, but subsided. “We waited on it it, and it faded. We realized it was a part of its fermentation process.”
There is a category of beer where yeast gets top billing, and that is Wild Ale. Wild ales are fermented with a combination, or mixed culture that will include Brettanomyces and other microbes, in addition to Saccharomyces. Crooked Stave from Denver, Colorado, is known for their sour and wild ales, and blending science and art.
But how wild is wild? And can you even quality control it?
“On wild and sour beers we don’t do a lot of lab work. We measure ABV, calories, and monitor fermentation,” said Jordan Fey, Crooked Stave’s Brewhouse and Quality Control Coordinator. “We run micro tests to make sure we’re not getting any souring bacteria in the stainless tanks, and want to make sure the souring is at the end.”
For these beers, they don’t worry about pitch rate. “One of the fun things for us is not adding yeast. We primary ferment in an open foeder, adding to the yeast cake in it.”
At Crooked Stave, while the “clean” and “sour” beers are fermented under the same roof, they ensure that there is no cross-contamination by a color-coding scheme. Everything Brett has a different color scheme than the Saccharomyces, so the equipment doesn’t get mixed up.
How sour is sour? Another flavor-facet that Crooked Stave tests for is sourness. “We run titratable acidity on our sour beer in the lab. This tests for the amount of lactic acid present in each sour and allows us to put a number to how sour a beer is,” said Fey. “We like to use this as an educational piece for the taproom, it gives the beertenders knowledge to pass on to consumers when someone walks in asking ‘how sour are your beers?’ or which is the least or most sour.”
While wild yeast can be harvested from the skins of fruit, or beards, or old barrels, home and commercial brewers can also buy wild yeast and mixed cultures from yeast banks like White Labs. They come complete with instructions and recommendations.
Throughout the ages, even as fermentation has been revered, yeast has been both misunderstood and omnipresent—in the air we breath, and on our skin. Through careful control and manipulation, brewers and the quality control managers make sure that yeast makes delicious, sophisticated, artisanal liquids instead of exploding into a disgusting cocktail of undrinkable off-flavors in your mouth. Civilization has always had a deep relationship with yeast and fermentation. Hops might have some puns, but yeast is a fun guy with a sweet tooth who is always there.


Share Post